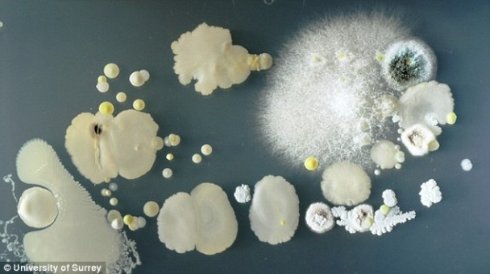
На поверхности смартфона обитает невероятное количество микробов (ФОТО)
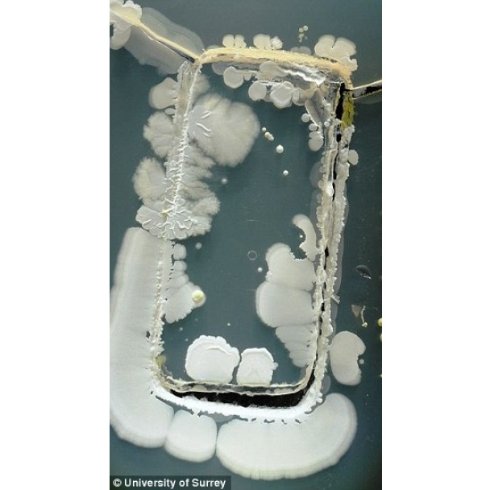
На поверхности смартфона обитает невероятное количество микробов (ФОТО)

Ученые рассказали, что на поверхности обычного смартфона содержится огромное количество бактерий, многие из которых могут стать возбудителями опасных заболеваний.
В большинстве случаев эти бактерии относительно безопасны — они оседают на поверхности в результате прикосновения грязных пальцев или немытых рук. По словам ученых, некоторые бактерии могут стать возбудителями серьёзных заболеваний, таких как пищевое отравление и сепсис.

Студенты университета Суррея в течении 3-х дней изучали уровень загрязнения мобильных телефонов. В итоге они обнаружили целый перечень опасных инфекций, окружающих смартфоны.


В их числе золотистый стафилококк, который может повлечь тяжёлое пищевое отравление.
«Количество бактерий, находящихся на поверхности телефона, может превышать количество бактерий, которые витают в туалете», — подытожили ученые.






